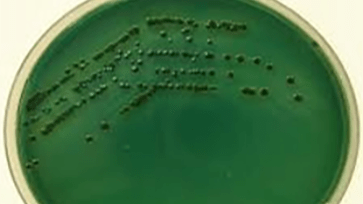
vibrio3
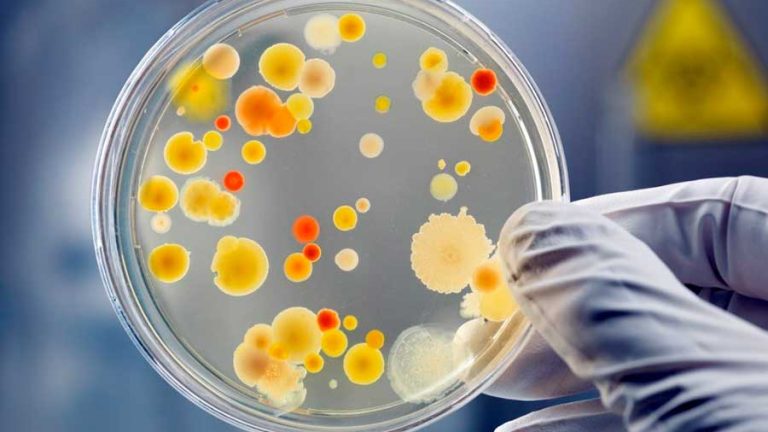
proyecto-20624

Facilitamos y fortalecemos la actividad sustantiva de investigación en la institución, participando en conjunto con la Dirección General, la Coordinación de Programas Académicos, la Coordinación de Vinculación y cada una de las Coordinaciones de Área, en la planeación, organización, integración, apoyo y seguimiento de las actividades científicas, tecnológicas y de innovación
Promovemos la productividad y calidad de los productos científicos derivados del trabajo transdisciplinario en grupos y rede
Facilitamos el acercamiento entre investigadores para la formación de grupos y redes de investigación e innovación científica y tecnológica, tanto al interior de la institución como hacia el resto de Centros Públicos de Investigación y organizaciones académicas nacionales e internacionales
Damos seguimiento al avance de los proyectos de investigación en apego a la razón de ser del CIAD: contribuir al desarrollo sustentable y al bienestar de la sociedad
Facilitamos y fortalecemos la actividad sustantiva de investigación en la institución, participando en conjunto con la Dirección General, la Coordinación de Programas Académicos, la Coordinación de Vinculación y cada una de las Coordinaciones de Área, en la planeación, organización, integración, apoyo y seguimiento de las actividades científicas, tecnológicas y de innovación
Promovemos la productividad y calidad de los productos científicos derivados del trabajo transdisciplinario en grupos y rede
Facilitamos el acercamiento entre investigadores para la formación de grupos y redes de investigación e innovación científica y tecnológica, tanto al interior de la institución como hacia el resto de Centros Públicos de Investigación y organizaciones académicas nacionales e internacionales
Damos seguimiento al avance de los proyectos de investigación en apego a la razón de ser del CIAD: contribuir al desarrollo sustentable y al bienestar de la sociedad
Grupos de Investigación
Grupos de investigación registrados en los que participan investigadores del CIAD


Grupos de Investigación
Lorem ipsum dolor sit amet, consectetuer adipiscing elit. Aenean commodo ligula eget dolor. Aenean massa. Cum sociis natoque penatibus et magnis dis parturient montes.
Proyectos vigentes

Convocatorias vigentes
Alertas de investigación: apoyos a la investigación, fondos internacionales, becas para estudios de posgrado, premios a la investigación y fondos para grupos y redes. Alertas de movilidad: convocatorias dirigidas a investigadores(as) y a estudiantes.